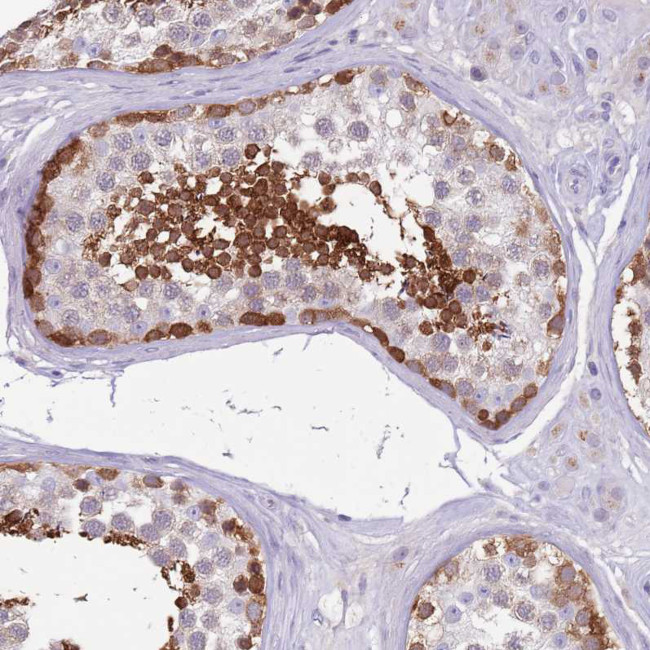
DDHD1 Antibody in Immunohistochemistry (Paraffin) (IHC (P))

Search
Invitrogen
DDHD1 Polyclonal Antibody
{{$productOrderCtrl.translations['antibody.pdp.commerceCard.promotion.promotions']}}
{{$productOrderCtrl.translations['antibody.pdp.commerceCard.promotion.viewpromo']}}
{{$productOrderCtrl.translations['antibody.pdp.commerceCard.promotion.promocode']}}: {{promo.promoCode}} {{promo.promoTitle}} {{promo.promoDescription}}. {{$productOrderCtrl.translations['antibody.pdp.commerceCard.promotion.learnmore']}}
产品信息
PA5-147206
种属反应
宿主/亚型
分类
类型
抗原
偶联物
形式
浓度
规格
纯化类型
保存液
内含物
保存条件
运输条件
RRID
产品详细信息
Immunogen sequence: NTAMMREAAR KIEERHFSNH ATHVEFLPVE WRSKLTLDGD TVDSITPDKV RGLRDMLNSS AMDIMYYTSP LYRDELVKGL QQELNRLYSL FCSRNPD
Highest antigen sequence identity to the following orthologs: Mouse - 98%, Rat - 98%.
靶标信息
This gene is a member of the intracellular phospholipase A1 gene family. The protein encoded by this gene preferentially hydrolyzes phosphatidic acid. It is a cytosolic protein with some mitochondrial localization, and is thought to be involved in the regulation of mitochondrial dynamics. Overexpression of this gene causes fragmentation of the tubular structures in mitochondria, while depletion of the gene results in mitochondrial tubule elongation. Deletion of this gene in male mice caused fertility defects, resulting from disruption in the organization of the mitochondria during spermiogenesis. In humans, mutations in this gene have been associated with hereditary spastic paraplegia (HSP), also known as Strumpell-Lorrain disease, or, familial spastic paraparesis (FSP). This inherited disorder is characterized by progressive weakness and spasticity of the legs. Alternative splicing results in multiple transcript variants encoding different isoforms.
仅用于科研。不用于诊断过程。未经明确授权不得转售。
篇参考文献 (0)
生物信息学
蛋白别名: DDHD domain-containing protein 1; intracellular phospholipase A1 alpha; lipase; PA-PLA1; Phosphatidic acid-preferring phospholipase A1 homolog; phosphatidic acid-preferring phospholipase A1-like protein; phospholipase; Phospholipase DDHD1; Phospholipid sn-1 acylhydrolase; spastic paraplegia 28 (autosomal recessive); unnamed protein product
基因别名: DDHD1; iPLA1alpha; iPLA1I; KIAA1705; PA-PLA1; PAPLA1; SPG28
UniProt ID: (Human) Q8NEL9
Entrez Gene ID: (Human) 80821